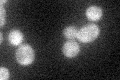
YKL025C
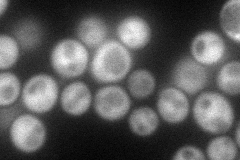
YKL025C
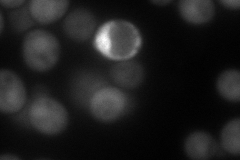
YKL025C
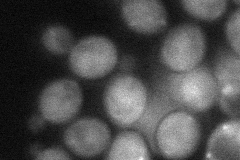
YKL025C
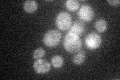
YKL025C

View description
Essential subunit of the Pan2p-Pan3p poly(A)-ribonuclease complex, which acts to control poly(A) tail length and regulate the stoichiometry and activity of postreplication repair complexes
Localization:
Intensity:
Fold change:
Significance:
-
C’ GFP library in SD
cytosol29.74 -
N' NOP1pr-GFP in SD
cytosol99.485 -
N' TEF2pr-mCherry in SD
nucleus99.2083 -
N' NATIVEpr-GFP in SD

below threshold24.5986 -
N' TEF2pr-VC and Cyto-VN in SD
cytosol50.9035 -
C’ GFP library in SD+DTT

cytosol33.321.12No -
C’ GFP library in SD+H2O2

cytosol37.181.24No -
C’ GFP library in Starvation Media
cytosol29.720.99No -
C’ GFP library on the background of Pup2-DaMP

N/A -
C’ GFP library on the background of CCT mutant

N/A0N/AYes
